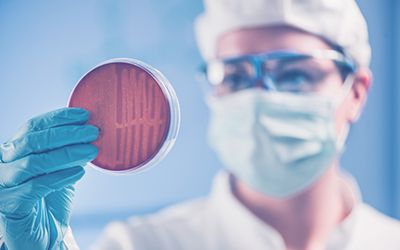
Wound Nail Dx

GTI Labs Services
Womens test panels coming soon!
GTI Labs has leveraged over 40 years of industry experience combined with the cutting-edge research and technology. Our team at GTI consists of scientists trained in Human Molecular Genetics, Board Certified Medical Doctors, and Professional Medical Sales Executives. As a team, we work to uncover and deliver targeted health insights to improve patient care. At GTI Labs our comprehensive services include:
Med Management
GTI Labs provides comprehensive Screening and Confirmation testing for Illicit and Prescription Drugs.
Learn MoreToxicology
Accurate urine drug testing with LC-MS/MS, providing reliable results on 110+ compounds to support patient safety and medication compliance.
Learn MoreRespiratory Pathogen Detection
FDA-cleared respiratory panel provides an overall sensitivity of 95% and specificity of 99%.
Learn MoreGastrointestinal
The Gastrointestinal (GI) Panel tests for common gastrointestinal pathogens including viruses, bacteria and parasites that cause infectious diarrhea.
Learn MoreUTI / STI Testing
Rapid and accurate solution eliminates guesswork in diagnosing and treating urinary tract infections.
Learn MoreWound Nail Dx
Rapid and accurate solution eliminates guess work in diagnosing and treating wound infections.
Learn MoreABR Testing
Identify resistant pathogens early to guide confident, effective antibiotic treatment.
Learn More